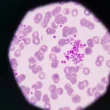

هل تعلم أن الفاكهة الخضراء الصغيرة المعروفة بالكيوي تحمل في طياتها كنوزًا صحية مذهلة، خاصةً لدمك وصحة جسمك العامة؟ كثيرون يستمتعون بطعمها المنعش، لكن قلة يدركون عمق فوائدها الطبية. الكيوي ليس مجرد إضافة لذيذة لوجباتك، بل هو قوة غذائية يمكنها أن تحدث فرقًا حقيقيًا في صحتك.
في هذا المقال، سنغوص عميقًا في عالم الكيوي لنكشف لك أبرز فوائده للدم وكيف يدعم أجهزتك الحيوية الأخرى. استعد لتكتشف لماذا يجب أن يكون الكيوي جزءًا أساسيًا من نظامك الغذائي اليومي.
محتويات المقال:
- فوائد الكيوي المدهشة للدم
- فوائد الكيوي الشاملة للجسم: أكثر من مجرد فاكهة
- الآثار الجانبية وموانع استخدام الكيوي
- الخلاصة
فوائد الكيوي المدهشة للدم
يتفرد الكيوي بخصائص فريدة تجعله حليفًا قويًا لصحة الدم. غالبًا ما يتم التغاضي عن هذه الفوائد القيمة، ولكنها تلعب دورًا محوريًا في حمايتك من العديد من المشكلات الصحية.
يمنع تخثر الدم
يحتوي الكيوي على مستخلصات طبيعية تمتلك تأثيرات قوية مضادة للصفائح الدموية. يعني هذا أن تناول الكيوي بانتظام يمكن أن يقلل بشكل كبير من خطر الإصابة بجلطات الدم الخطيرة والسكتات الدماغية.
علاوة على ذلك، يعمل الكيوي على تحسين عملية انحلال الفبرين، مما يؤثر إيجابيًا على الأوعية الدموية ويقي من تصلب الشرايين والانصمام الخثاري، ويحافظ على سيولة الدم الصحية.
يحسن امتصاص الحديد
يعد الكيوي مصدرًا ممتازًا للمواد الكيميائية النباتية، مثل اللوتين والزياكسانثين، بالإضافة إلى كميات وفيرة من فيتامين ج. هذه المركبات تعمل معًا بانسجام لمنع اضطرابات نقص الحديد في الجسم.
عندما تتناول الكيوي مع الأطعمة الغنية بالحديد، مثل حبوب الإفطار المدعمة، فإن فيتامين ج يعزز امتصاص الحديد بشكل ملحوظ، مما يضمن حصول جسمك على كفايته من هذا المعدن الحيوي.
يمنع الإصابة بفقر الدم
كل ثمرة كيوي تحتوي على حوالي 56 ملليغرام من فيتامين ج، وهو ما يمثل 75% من القيمة اليومية الموصى بها للنساء و62% للرجال. يلعب فيتامين ج دورًا حيويًا في تحسين امتصاص الحديد، كما ذكرنا سابقًا.
بفضل هذه الخاصية، يساهم تناول الكيوي بانتظام في درء خطر الإصابة بفقر الدم الناجم عن نقص الحديد، مما يحافظ على مستويات الطاقة لديك ويمنع الشعور بالإرهاق والخمول.
فوائد الكيوي الشاملة للجسم: أكثر من مجرد فاكهة
بعيدًا عن دوره المحوري في صحة الدم، يقدم الكيوي مجموعة واسعة من الفوائد الصحية التي تشمل تقريبًا كل جهاز في جسمك. اكتشف كيف يمكن لهذه الفاكهة الصغيرة أن تحدث فرقًا كبيرًا:
يعالج الربو ويحسن صحة الجهاز التنفسي
يساعد المحتوى العالي من فيتاميني ج وهـ في الكيوي على تخفيف أعراض الربو. بالإضافة إلى ذلك، يعزز الكيوي المناعة ويحارب الإجهاد التأكسدي، مما يقلل بدوره من الالتهابات التي تصيب الجهاز التنفسي العلوي ويمنحك نفسًا أسهل.
يعزز صحة الجهاز الهضمي
يحتوي الكيوي على نسبة جيدة من الألياف الغذائية التي تدعم عملية الهضم الصحية. هذه الألياف تساعد في علاج مشكلات الجهاز الهضمي الشائعة مثل الإمساك والإسهال، وتضمن حركة أمعاء منتظمة.
يحتوي الكيوي أيضًا على إنزيم الأكتينيدين الفريد، الذي يسهل هضم البروتينات ويعزز الأداء العام للجهاز الهضمي، مما يجعلك تشعر بالراحة والنشاط.
يدعم مكافحة السرطان
يساهم الكيوي في الوقاية من السرطان ومكافحته بفضل محتواه الغني بفيتامين ج، وهو مضاد أكسدة قوي يحارب الجذور الحرة الضارة التي قد تسبب تلف الخلايا. كما تحتوي أليافه على مركبات مكافحة للسرطان، خاصة تلك التي تستهدف الجهاز الهضمي.
إضافة إلى ذلك، يضم الكيوي أنواعًا عدة من المركبات النشطة بيولوجيًا، مثل السلفورافين والإيزوسيانات والإندولات، والتي أظهرت قدرتها على تثبيط نمو الخلايا السرطانية.
يقوي صحة القلب والأوعية الدموية
البوتاسيوم الوفير في الكيوي ضروري لصحة القلب. فهو يقلل من خطر الإصابة بأمراض القلب عن طريق خفض مستويات الدهون الضارة في البلازما وتقليل فرط نشاط الصفائح الدموية، مما يساهم في الحفاظ على صحة الشرايين.
ليس هذا فحسب، بل يعمل الكيوي أيضًا على خفض مستوى ضغط الدم، مما يقلل العبء على قلبك ويحميك من مضاعفات ارتفاع الضغط.
يساعد في تنظيم السكري
تشير الدراسات إلى أن استهلاك الكيوي قد يحسن حساسية الأنسولين، وهو أمر حيوي لمرضى السكري أو المعرضين للإصابة به. كما أن محتواه العالي من الألياف الغذائية يساعد في تنظيم مستويات السكر في الدم، ويمنع الارتفاعات المفاجئة.
يكافح الالتهابات
يساهم الكيوي بقوة في محاربة الالتهابات المختلفة في الجسم. تساعد مضادات الأكسدة ومركباته النشطة في التخفيف من حالات الالتهاب مثل التهاب أنسجة القولون والتهاب الأمعاء، مما يعزز الشعور العام بالراحة والصحة.
يساعد في إدارة الوزن
مع محتواه المنخفض جدًا من السعرات الحرارية ومحتواه العالي من الألياف، يعتبر الكيوي إضافة مثالية لأي نظام غذائي يهدف إلى إنقاص الوزن. الألياف تمنحك شعورًا بالشبع لفترة أطول، مما يقلل من الرغبة في تناول الطعام ويساعدك على التحكم في شهيتك بفعالية.
يعزز قوة النظر وصحة العين
فيتامين ج الموجود في الكيوي هو أحد أقوى مضادات الأكسدة التي تساعد على تجديد خلايا وأنسجة العين، وتحميها من التلف. بالإضافة إلى ذلك، يحتوي الكيوي على اللوتين والزياكسانثين، وهما مركبان يعززان صحة العين بشكل كبير.
هذه المركبات تعمل على منع الإصابة بالضمور البقعي المرتبط بالتقدم في السن، وتحافظ على حدة بصرك وسلامة عينيك.
الآثار الجانبية وموانع استخدام الكيوي
على الرغم من فوائد الكيوي العديدة، يجب أن تكون على دراية ببعض الآثار الجانبية المحتملة، خاصةً إذا كنت تعاني من حساسية تجاه هذه الفاكهة.
أعراض الحساسية الخفيفة
قد يعاني بعض الأشخاص من حساسية تجاه الكيوي. تشمل الأعراض الخفيفة التي قد تظهر بعد تناوله:
- الطفح الجلدي.
- الحكة أو الشعور بالانزعاج في اللسان أو الشفتين.
متى يجب استشارة الطبيب؟
في بعض الحالات، قد تتطور حساسية الكيوي إلى أعراض شديدة تتطلب عناية طبية فورية. توجه إلى أقرب مركز طبي إذا واجهت أيًا من الأعراض التالية:
- التقيؤ الشديد.
- الشعور بالدوار والدوخة.
- صعوبة في التنفس.
- ألم حاد في البطن.
- تورم ملحوظ في الفم أو الحلق أو الشفتين.
الخلاصة
يُعد الكيوي فاكهة استثنائية تقدم مجموعة واسعة من الفوائد الصحية، خاصةً لصحة الدم والجسم بشكل عام. من قدرته على منع تخثر الدم وتحسين امتصاص الحديد ومكافحة فقر الدم، إلى دعمه للجهاز الهضمي والمناعي والقلب والعينين، يثبت الكيوي أنه إضافة قيمة لنظامك الغذائي.
إن إدراج هذه الفاكهة اللذيذة في نظامك الغذائي اليومي يمكن أن يكون خطوة بسيطة لكنها قوية نحو تحسين صحتك وحيويتك. استمتع بفوائده العديدة، ولكن كن واعيًا لأي ردود فعل تحسسية محتملة.